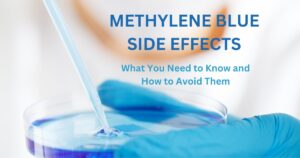
Add a heading

Blog
Methylene Blue Side Effects: What You Need to Know and How to Avoid Them
Methylene blue has garnered attention in recent years for its potential to enhance cognitive function, support mitochondrial health, and offer neuroprotection. As more people explore


